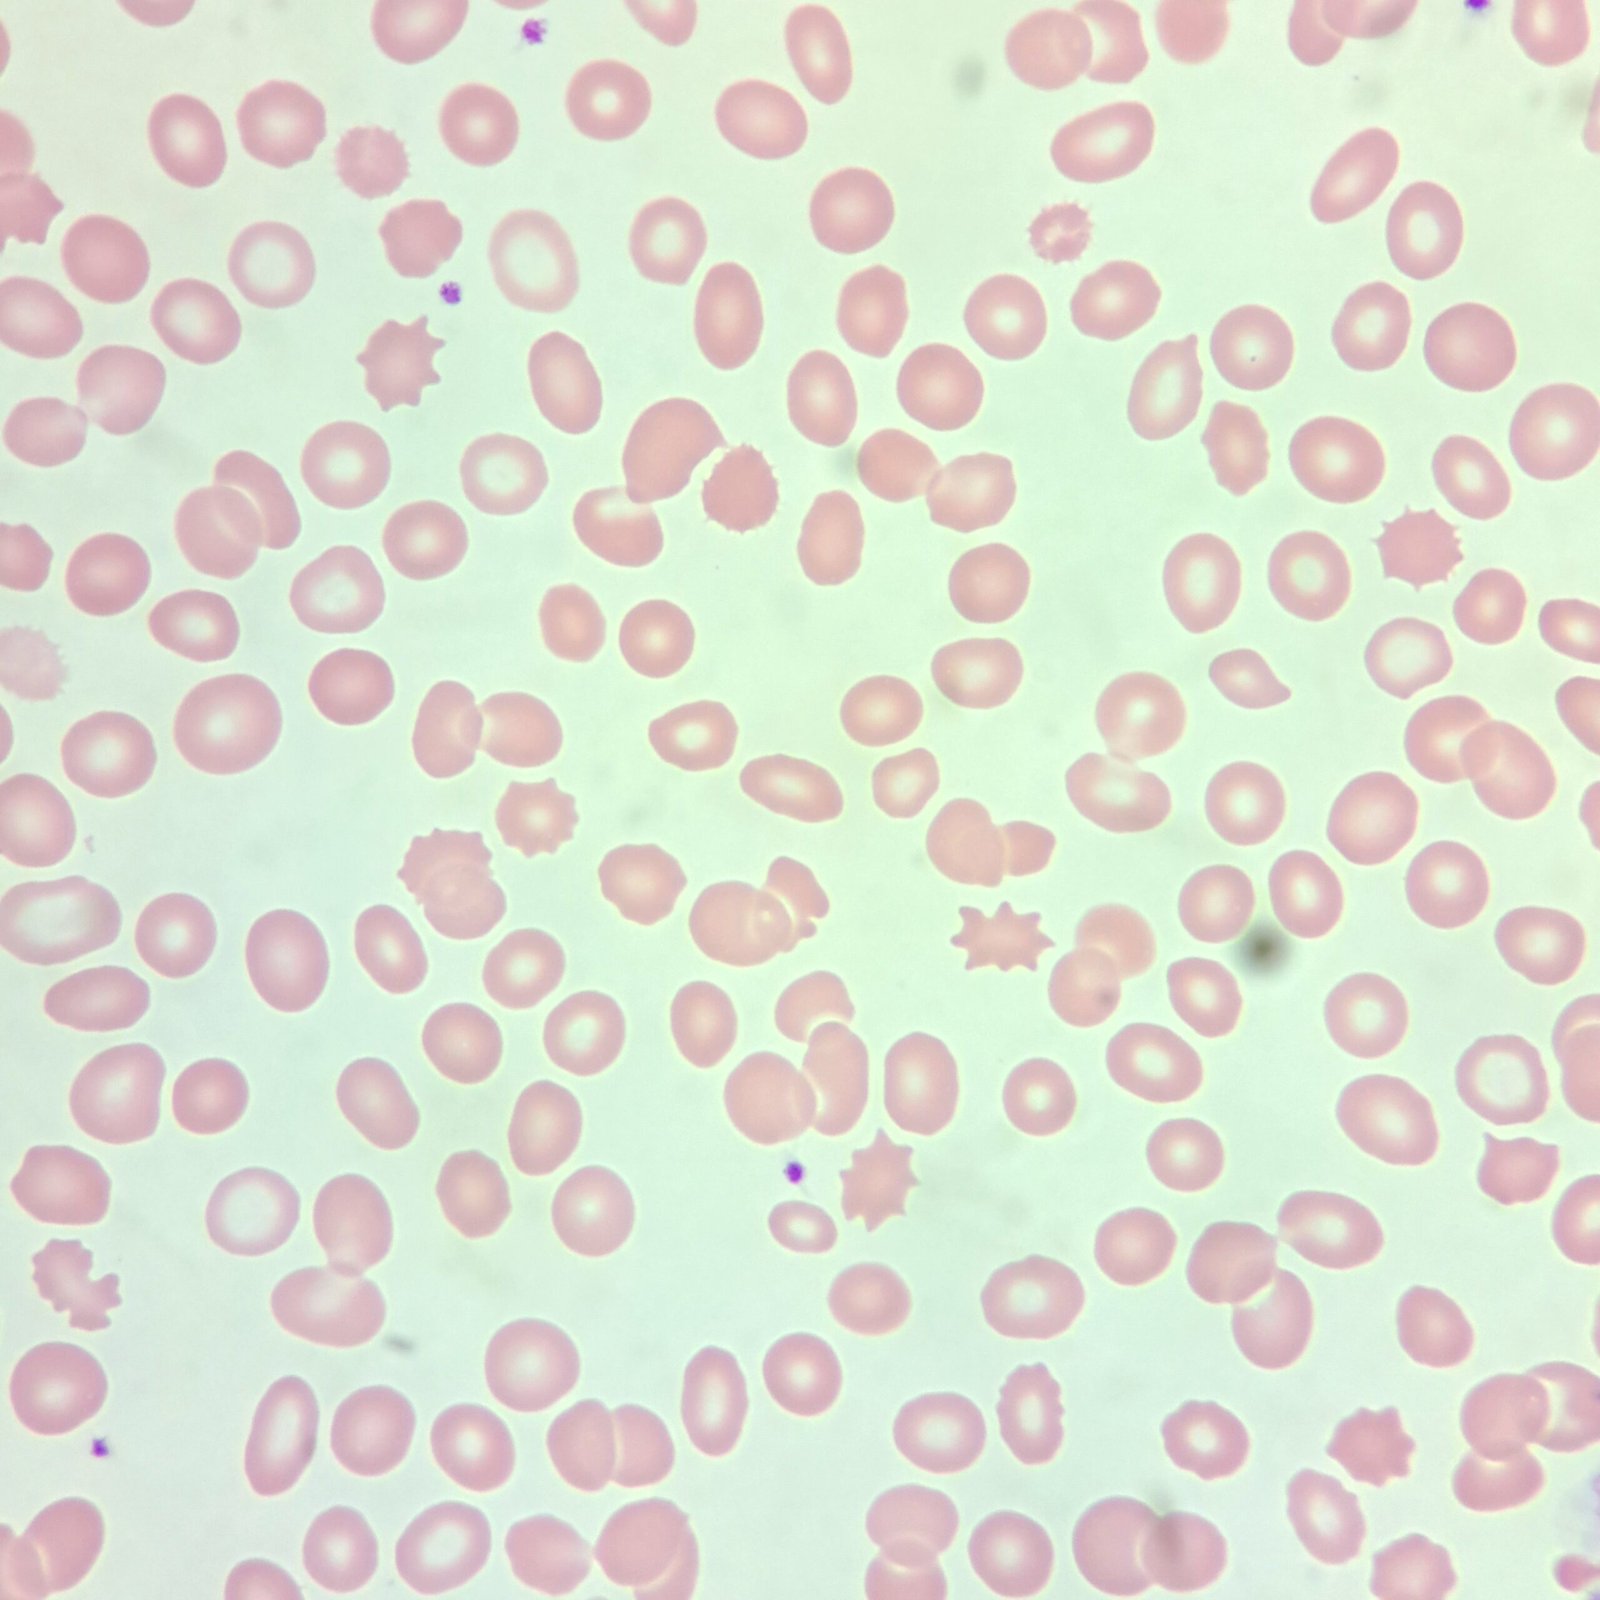
Acanthocytes, Red Blood Cell Morphology

Burr cells are also known as echinocytes. This term comes from the prefix echino which refers to something spiny or prickly and comes from the Greek word for hedgehog, ekhinos.
These cells can be artifactual due to slide preparation and should be suspected when found in large numbers or only in certain areas of the slide.
True burr cells are seen in uremia, renal insufficiency, cirrhosis, severe dehydration, burns, etc.
Appearance
Burr cells have evenly distributed “bumps” along their surface. Central pallor is still visible.

Lookalikes
Acanthocytes can be confused with burr cells. However, acanthocytes lack central pallor. Their projections are fewer in number and also more uneven.
Bench Tip: Burr cells are bumpy, Acanthos are funky!
Quick Summary
- Also Known As:
- Echinocytes
- Morphology/Appearance:
- Evenly distributed bumps along the cell membrane
- Clinical Significance:
- Uremia
- Renal Insufficiency
- Cirrhosis
- Severe Dehydration
- Burns
- Common Lookalikes
- Acanthocytes which have fewer and more irregular projections
Gallery


References
Authored by Rachel Harper, Medical Laboratory Scientist (ASCP)
Last reviewed: February 2026
For educational and reference purposes only, this is not medical advice.